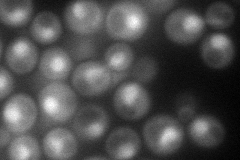
YLR055C
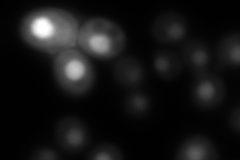
YLR055C
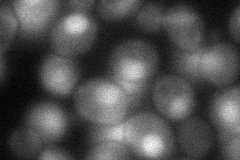
YLR055C
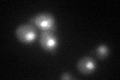
YLR055C
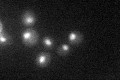
YLR055C

View description
Subunit of the SAGA transcriptional regulatory complex but not present in SAGA-like complex SLIK/SALSA, required for SAGA-mediated inhibition at some promoters
Localization:
Intensity:
Fold change:
Significance:
-
C’ GFP library in SD

nucleus26.29 -
N' NOP1pr-GFP in SD
cytosol,nucleus93.6997 -
N' TEF2pr-mCherry in SD
cytosol,nucleus184.578 -
N' NATIVEpr-GFP in SD

nucleus18.7989 -
N' TEF2pr-VC and Cyto-VN in SD
nucleus59.3563 -
C’ GFP library in SD+DTT
nucleus32.311.22No -
C’ GFP library in SD+H2O2

nucleus33.891.28No -
C’ GFP library in Starvation Media
nucleus29.461.12No -
C’ GFP library on the background of Pup2-DaMP

nucleus -
C’ GFP library on the background of CCT mutant

nucleus28.1551.07029No
